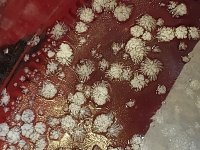
20230514_114720.jpg

Madhattress
Established member
Hey guys,
So i am going to do my first extraction the weekend using Normans tek.
Just wondering if i can add all the solvent pulls into one jar or if it has to be multiple jars for each pull as i read in the recipe?
Do i cover the solvent jar with cling wrap before the freezer or can i use lids to close the jar?
Any other tips using the extraction tek will be appreciated.
So i am going to do my first extraction the weekend using Normans tek.
Just wondering if i can add all the solvent pulls into one jar or if it has to be multiple jars for each pull as i read in the recipe?
Do i cover the solvent jar with cling wrap before the freezer or can i use lids to close the jar?
Any other tips using the extraction tek will be appreciated.

.
.